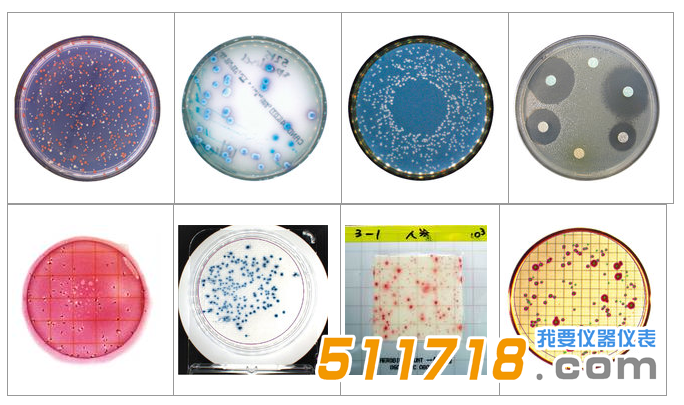
1534146096341502.png 法國(guó)interscience Scan 1200自動(dòng)菌落計(jì)數(shù)器1.png

法國(guó)interscience Scan 1200自動(dòng)菌落計(jì)數(shù)器適應(yīng)與實(shí)驗(yàn)室里*有的媒介,使用*適,精率高。
法國(guó)interscience Scan 1200自動(dòng)菌落計(jì)數(shù)器產(chǎn)品簡(jiǎn)介:
Scan? 1200 高分辨率全自動(dòng)彩色菌落計(jì)數(shù)器,適應(yīng)與實(shí)驗(yàn)室里*有的媒介,使用*適,精率高。具有良好的重現(xiàn)性,自動(dòng)保存圖像和數(shù)據(jù)結(jié)果。
法國(guó)interscience Scan 1200自動(dòng)菌落計(jì)數(shù)器主要特點(diǎn):
1. HIGH RESOLUTION & 高性能
很小菌落的大小 : 0.05毫米
在1秒內(nèi)能夠檢測(cè)到1000個(gè)菌落
活動(dòng)目標(biāo)影像 (數(shù)字變焦 x28)
在5分鐘內(nèi)可接種30個(gè)培養(yǎng)皿(在預(yù)先調(diào)整的情況下)
Fully automatic lighting: lights controlled by computer and motorized background color
2. 可計(jì)數(shù)類型
3. SOFTWARE EFFICIENCY
*有功能只需一個(gè)窗口
自動(dòng)調(diào)整亮度及對(duì)比度
Automatic corrections of the agar defects
自動(dòng)分離融合的菌落
計(jì)數(shù)網(wǎng)格自動(dòng)取消
每一個(gè)菌落都會(huì)用叉號(hào)標(biāo)記
多邊形排除區(qū)域
Pre-set medias: PCA/TSA, MRS, VRBL, TBX, TSC, Baird Parker, GVPC, L.Mono, YM
4. INHIBITION ZONE, AGAR WELL
Rapid detection: up to 8 antibiotic sensitivities in 1 click
Inhibition zones and agar wells can be manually added or deleted
Built-in antibiotic database (CA-SFM, French Society of Microbiology)
Precision of inhibition zone measurement: 0.3 mm
Precision of agar well measurement: 0.3 mm
Reads on: Muller Hinton agar, blood agar, chocolate agar
5. FULL TRACEABILITY
Harmonization of the results within a team
Automatic archiving and printing of data: pictures, comments & results
External traceability (Session saved, Excel?, PDF, JPEG, BMP, Scan? printed report)
Internal traceability (Barcode, file archive, LIMS connection)
Securization of the sessions (Compliance with CFR 21 part 11: system securization, operational controls and documentation management)
6. EXCELLENT REPRODUCIBILITY AND REPEATABILITY
GLP (Good laboratory Practice)
CFR 21 Part 11
Scan? SOFTWARE
Scan? automatic colony counters use an exclusive software developped by INTERSCIENCE: evolutive, user-friendly and powerful.
There are numerous advantages in using Scan? counting software:
Only one clic to count
Only one setting cursor
Traceability: automatic saving of data, Excel? export
To try the demo version with your samples, please identify below or register here
下載Scan試驗(yàn)版軟件。
1. VISUALISATION WINDOW
Detected colonies are highlighted and marked with a cross.
2. PARAMETERS WINDOW
Only one cursor to optimize counting. customizable settings adaptable to any kind of agar.
3. RESULTS WINDOW
All previously recorded data can be checked anytime.
EASY DATA EXPORT:
Scan? software provides easy ways to export quickly your results:
Work sessions saving
PDF export
JPEG, BMP export
Results exported to Excel?
Scan? printed report
EXAMPLE OF A SCAN? PRINTED REPORT:
Check in a glance images before and after counting, complete sample information, comments and results.
